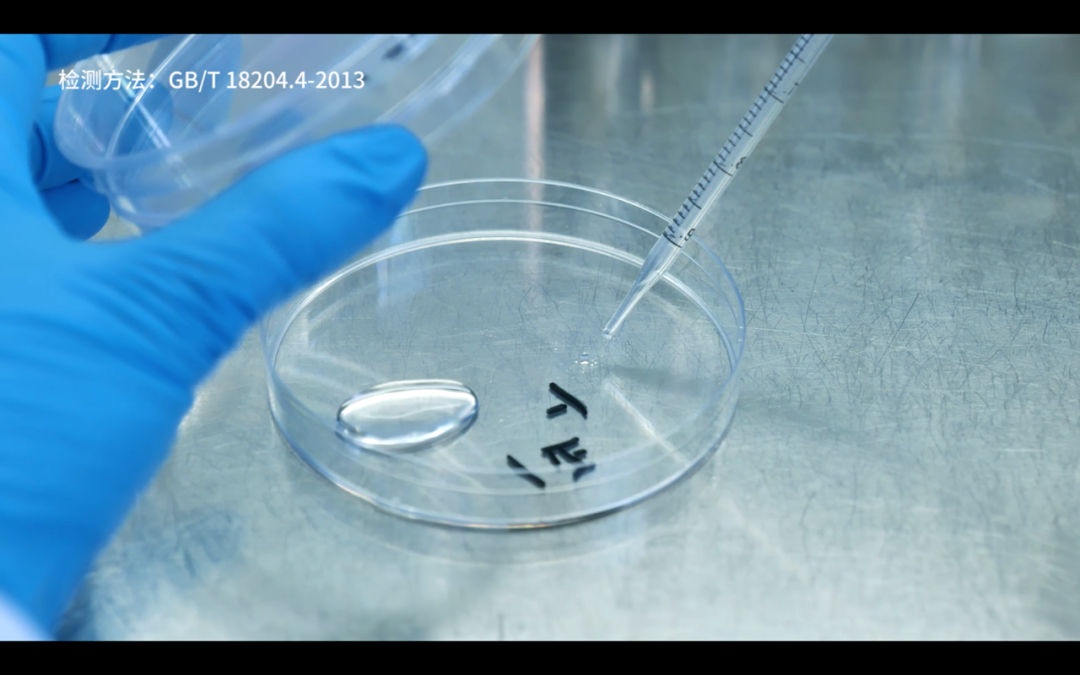
表面比马桶还脏?共享充电宝横评

中国有多少共享充电宝? 自称市场占有率第一的怪兽充电,官网显示拥有超过 5 亿个充电宝,我简单算了算,按照每个充电宝 362.5px 的长度计算,足够绕地球赤道一圈,再绕月亮三圈。

然而我们在券商研报上复查时,券商又说怪兽充电只有 500 万个充电宝,再对照怪兽充电的招股书:果然,官网上的牛皮吹得太大了,哎 难怪它们股票的颜色如此生机盎然。

不过 500 万也不是个小数目,从广东广州能一路平铺到湖南长沙。
可即使已经多到用不完,也丝毫不影响共享充电宝涨价。现在在一些热门景区、车站、机场,你可以享受到 10 元 1 小时的 10 瓦慢充尊贵体验。即使在市区的商场里,共享充电宝的价格也已经翻了几倍,从原来的每小时 1 元,涨到了 3 元、4 元。价格人人都在吐槽,但大家有没有想过另一个问题:商场里那么多共享充电宝,每天用来用去,你见过有人给它们消毒么?它们的表面细菌是不是也被共享了呢?另外这些押金 99 元的充电宝实际成本到底是多少?

共享充电宝有多脏?
为了回答这个问题,我们在公司附近的商场里,直接购买了怪兽充电、小电、街电三家的充电宝。

为了避免造成二次污染,送测之前,我们根据 xx 操作手册,严格密封保存这些共享充电宝,并在当天就送到了凰家评测深度合作的微生物实验室,检测一下到底这些共享充电宝到底有多脏?谁最脏。

我们依照《公共场所卫生检验方法国家标准》,对三款充电宝的正反面分别进行了取样、稀释,之后加入营养琼脂培养基,等待培养基凝固之后,在培养箱中以 37 度恒温倒置培养 48 小时。

菌落总数实验的结果显示: 怪兽充电相对比较干净,每平米菌落总数 8000CFU,应该还是定期做过清洁消毒的。而街电和小电的表面菌落数分别高达每平米 21.6 万 CFU 和 44 万 CFU。

一般来讲,自媒体习惯拿来举例的马桶,表面菌落总数通常在每平米 8 万 CFU 左右。

照这么说,小电和街电的外表面确实比马桶细菌更多。
但是,作为一家 b 站上数一、数二、数三、数四…… 的评测机构,我们可不能如此贩卖焦虑。
实验室的研究员告诉我,他们平时测试酒店的毛巾,清洁做的比较差,一般菌落数也就在每平米几万 CFU 的水平。

所以大家也不用过分担心,在日常生活中,接触细菌是不可避免的,关键在于自己勤洗手勤消毒。
比如你取完充电宝用酒精湿巾擦一擦、或者多洗几次手,就能很有效的杀灭细菌。
然而你要是一边拿着充电,一边吃饭。那我就不多说了,你自己想吧。

尊贵的慢充体验?
我们再来看看这些充电宝其他方面表现怎么样?
我们在相同的设备上再次采购了这三家的充电宝,并且找了一台电池健康 100% 的 iPhone 11,模拟真实使用场景,测试了这三款“价值 99 元”充电宝的充电速度。(每次充电前,将手机电量控制在 20%,之后每 15 分钟,记录一次电量的变化)

结果和预想的差不多,三款产品的充电速度相差不大,都是半小时充入 36、37%,一小时充入 65、66%,完全充满耗时 100 分钟左右。
很好计算,三款充电宝的输出功率都是 10 瓦左右。

在测试当中,怪兽充电的充电宝不够稳定,多次充到 80% 电量就自己停了。

我就想问,这是父母告诉你,累了就歇歇,还是你在帮手机电池保健,让它别吃太撑?关键问题是,这样的充电宝 —— 是我花 99 买的啊!
我非常温柔的拆解了这三款共享充电宝,它们的内部构造差不多,都是锂电芯、主板、外壳、充电线的简单构造。

类似的主板在阿里巴巴(去看看阿里妈妈的价格)的价格不超过 20 元,5000 毫安时锂电芯价格也在 20 元左右,加上外壳、电线等非核心配件,整套的成本约 50 元,考虑到这些企业少则数万,多则数百万的拥有量,它们的采购成本肯定更便宜。


而即使是在电商零售平台,我们也能花 50 元买到 10000 毫安时、13W 输出、Type-C 接口的大品牌移动电源。

也就是说,这些 N 手的共享充电宝卖 99,每台利润超过 40 元,算是暴利了。
我裂开了
作为用过、拆过以及丢过 N 多充电宝的人,坦诚的讲,他们这种充电宝,超过 50 块都不要买。
日常使用时,半小时内的短时补电,街电价格最优,1 小时内的充电中,小电和街电价格相差不大。怪兽充电。。。。网点最多。
钱都去哪儿了?
我们在研读怪兽的招股书发现,2020 年,怪兽充电的营收实现了接近 40% 的增长,总营收高达 28 亿。然而净利润却从 1.66 亿降到了 7 千 5 百万,连 19 年的一半都不到,钱都去哪了呢?

2020 年,怪兽充电收入 75.5% 都用在了销售和营销费用上,相比 2019 年增长 55.7%。三电一兽的激烈竞争,让线下抢占充电位的成本越来越高。

那这些企业缺钱么?然而不同于其它共享经济的产品,共享充电行业的激烈竞争,并没有让消费者得到真正的好处。
三电一兽虽然表面打得火热,但面对消费者,它们的步调惊人的一致:5000 毫安时小容量、10 瓦慢充、老式接口;以及涨价、涨价、再涨价。
毕竟在几家注册用户都过亿的当下,涨价是最直接有效的增收手段。当你手机快没电时,你在乎的也不是性价比,而是谁家的充电宝在你眼前。
我们不排斥商业创新,不反对共享经济。
但我们不妨退后一步,想想一开始我们是怎么定义共享经济的:
共享经济:是指拥有闲置资源的机构或个人,将资源使用权有偿让渡给他人,让渡者获取回报,分享者通过分享他人的闲置资源创造价值。

共享经济的存在,是为了让闲置资源能有再次利用的可能。
上一篇:为什么别人的一个网站能做这么多词
下一篇:没有了

 2021-04-16 08:19:27
2021-04-16 08:19:27












